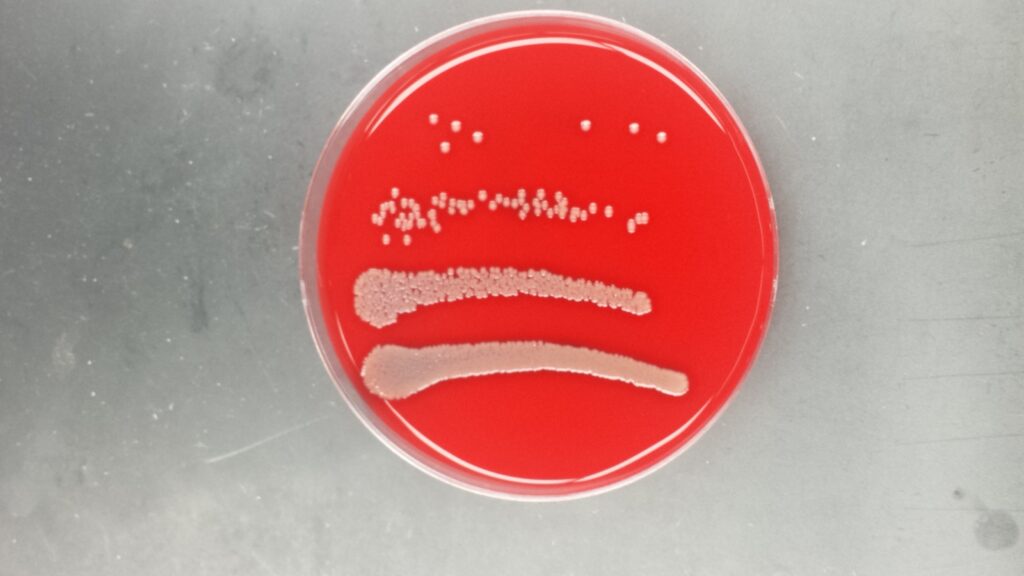
Plating MSSA

Rant: Residency was not harder back in your day
As a new attending, I don’t believe I can go a week or two without some older physician telling me how much harder things were when they trained. This seems to come up as a natural progression when someone notices that I’m new and asked where I trained. Soon after I reply comes the comments about how their training was somehow more difficult. I get it, the older physicians may feel that the younger physicians have it too good these days. There is no way to know who truly had a more emotionally or physically draining experience in residency unless someone decided to go back to residency for a career change at different decades in their career. Have you ever met anyone who has done such a thing? I personally have not.
A different generation
Not long ago I was talking with a physician who I have immense respect for. He obtained his medical degree in the late 50’s and his medical license in the 1960’s. He still helps educate and mentor medical residents, including me. (See the pictures below as he had me draw blood cultures from a bacteremic patient in order to preform our own test for antibiotics. He then had me plate it and check penicillin in combination with gentamicin to see the synergistic effect for myself.) The conversation I had with him as a new attending was eye opening to say the least as we discussed the changes to medial education in residencies over the years.
He described when he was a resident that CPR was just starting to become a widespread practice. I thought he might be over exaggerating till I went home and went right to the source everyone goes to first, wikipedia. He was telling the truth. He described his nights of admitting 3-4 patients to the hospital and being called to start morphine drips on patients where death was imminent. There were no codes, no HIV, no MRD organisms, and of course no LVAD’s or ECMO. He did tell me that he may have spent more nights in the hospital compared to the newer generation, but that his stress level was far less than what new physicians go through.
Medical advancements sure have come a long way since then. Patients are living longer with more complex medical issues. The problem is not that the patients may have more medical problems now, or that the hours may or may not be more difficult, but the attitude that some older physicians harbor against new physicians.

Hazing by working excessive hours
The problem is that physicians still see working hard as a competition. Who can struggle the most and make it though seems to be a badge of honor. Many physicians that make these arguments often come off as boisterous about how terrible things were for them and in essence look down at the younger generation for not having a similar experience. Whether this is true or not is not the issue. I had many nights in residency that were so stressful that I would be lying if I said I didn’t think about quitting medicine.
I don’t see this type of mentality dying anytime soon. Each week I can find an example of a physician perpetuating this type of behavior. For example, one physician I know goes out of his way to let everyone know that he has worked 5 days in a row working nights and days without a day off. When he tells the younger doctors about this he seems to laugh and tell us that younger physicians would never even consider this because we were not worked hard enough in residency.
Even the ACGME seems to be backtracking on duty hours. Not long ago they proposed getting rid of the 16 hour duty hour limit for interns. Each program is also different in their attitude towards residents well being. I know that at the residency where I trained it was not uncommon for people to simply put in whatever hours they felt like to avoid the 80 hour mark. There were several weekends as a resident where I never left the hospital for 48 hours straight and I graduated in 2016.

Financial burden
Another aspect of medical education that has changed not for the better is the financial burden of becoming a doctor. The average debt is around $200,000 for a graduating physician with a yearly pay of $50,000. Starting with a debt to income ratio of 4 is not setting new physicians up for financial success. Yes, incomes do balloon soon after graduation but the interest also continues to accrue leading to some physicians debt close to half of a million dollars by the time they are an attending. This on top of most residencies no longer providing food adds even more financial pressure to residents. Some programs, such as the one I went to, even have residents pay for parking. I paid close to $200 a month for parking alone, which was about 7% of my net paycheck each month. The days of free food provided by drug reps for residents have been long gone for several years now.
So before the older physicians judge me as having it too easy, try to consider newer physicians training. Graduating $200,000 or more in debt, with no free food, parking paid by the resident, and increased time spent trying to document in cumbersome EMR all while making $50,000 with rents taking a large chunk of that pay. There were nights were I had 3 codes, 10 admissions, and cross cover on 200+ patients where I went home thinking about quitting medicine. This was in addition to working a full day the day before my call and then rounding the following day while still seeing all my patients to write notes on them. Almost never was this accomplished in a 28 hour shift, leading to many days of breaking duty hours.
I would never wish that level of stress on anyone and I hope that soon that culture will change so that the almost hazing like attitude to residents in training ends. I am all for excellent clinical experience, but the attitude towards training new residents by forcing long hours with little pay and being told things were worse back in the day is not a movement in the right direction. The next time someone tries to tell me how hard their training was and how easy mine was without knowing what I went though, I’ll keep doing what I have been doing. Smile, say that’s nice and move on. I hope that slowly these attitudes towards practicing medicine will change.

